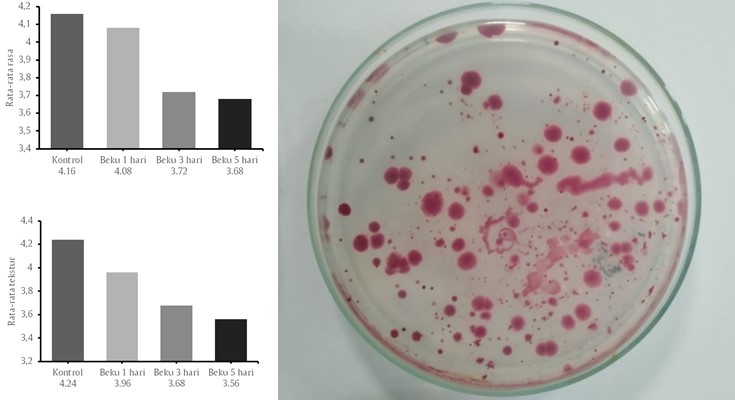

Sustainability status of People's Salt Pond Businesses in the coastal area of Labakkang District Pangkep Regency
Labakkang District is the only coastal district in Pangkep Regency that has the potential for salt pond business activities. The people's salt farming business is a business that has been carried out by the people in this area for a long time, but there are several problems, namely the large amount of unused land, low quality of salt, low selling price and lack of market absorption, therefore a study is needed to see the sustainability status of the business. the. This research aims to determine the sustainability status of people's salt businesses in Labakkang District, Pangkep Regency. The analytical method used in this research is sustainability status analysis with "SIOS" (sustainability index of salt) modified from the Rapfish analysis program. to find out the sustainability status of the people's salt business. Based on the results of the analysis of sustainability status using the sustainability index approach, it shows that the value of the ecological dimension (85.98), the economic dimension (80.79) and the institutional dimension (75.91) are all included in the sustainable category, while the value of the social dimension is (57.63). falls into the moderately sustainable category.
- Abdul RaufAbdulRauf
- Kamil YusufKamilYusuf
- Muhammad YunusMuhammadYunus
- Andi Muhammad Ilham RaufAndiMuhammad IlhamRauf